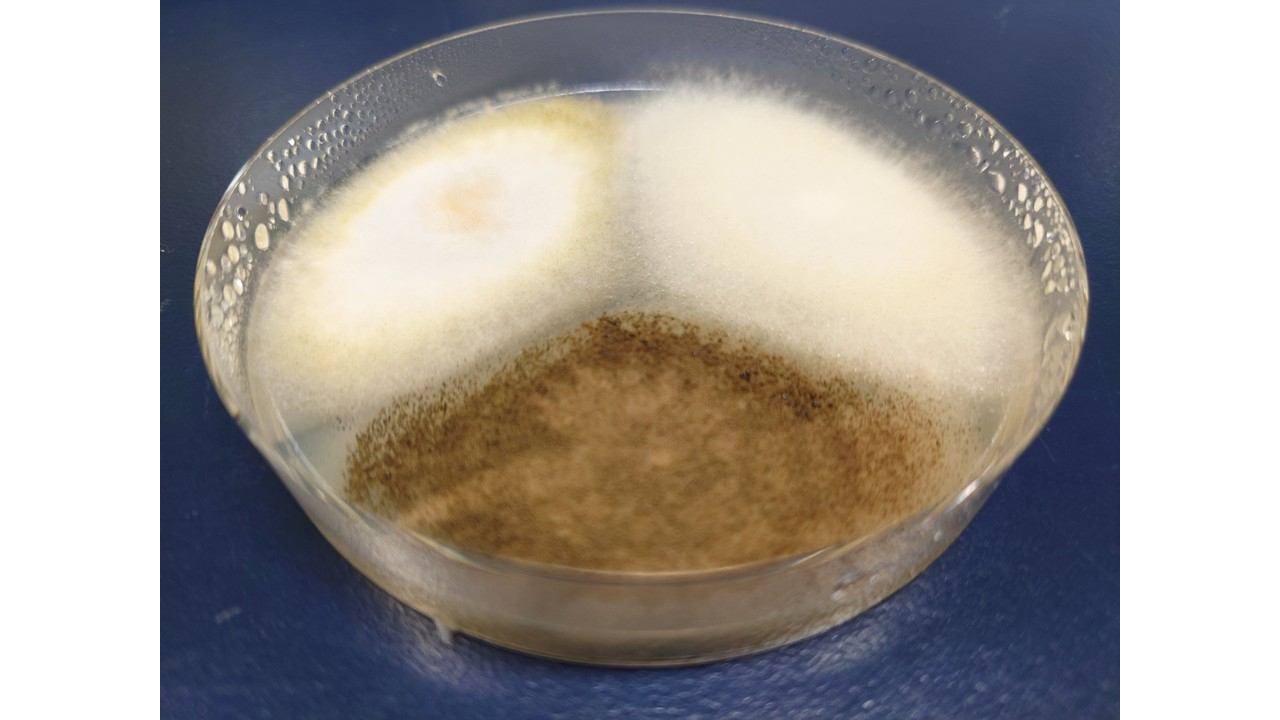
かび1.jpg
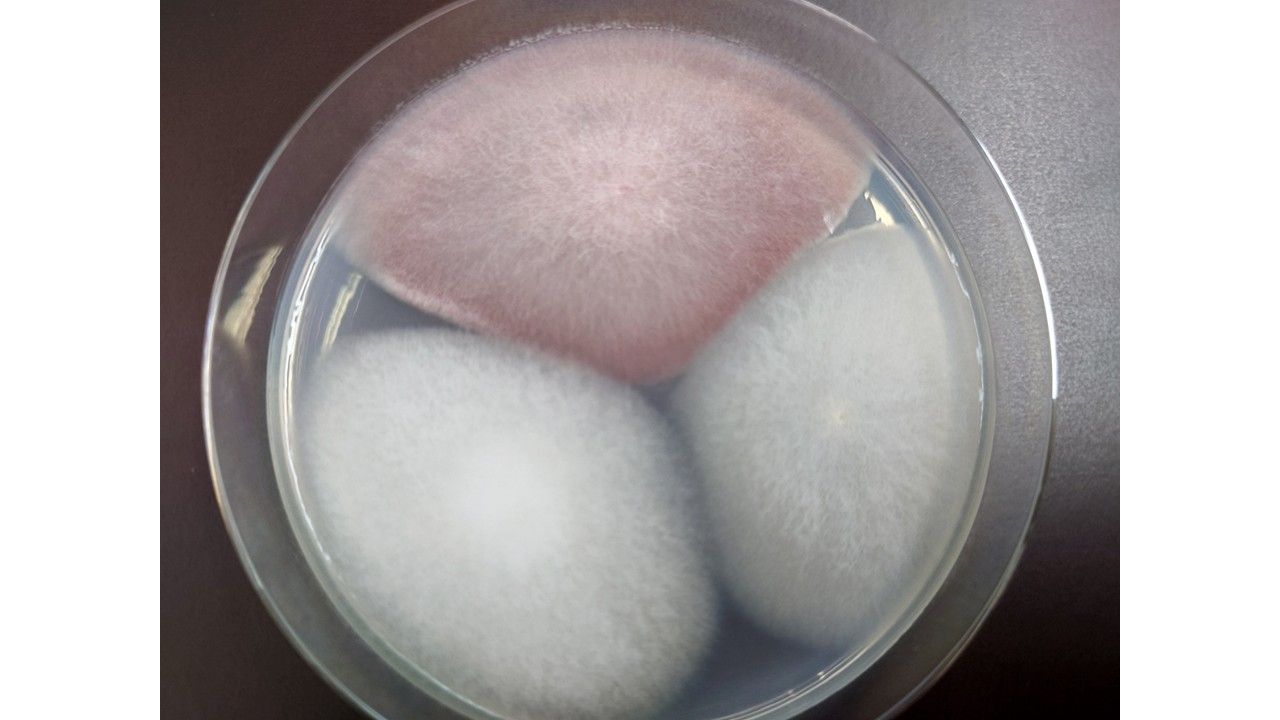
カビ2.jpg

こんにちは
ようやく暖かくなって春を感じます。
春になって自作の発酵食品づくりに挑戦したいなと思う方も多いと思いますが危険性も知っていただきたいと思います。
コウジカビは国菌といわれるくらい日本で利用されるカビで味噌、醤油、日本酒などの製造に欠かせないカビですが見た目ではどんなカビなのか全くわかりません。
上の写真は すべてコウジカビですが米麹、豆麹、黒麹になります。
学名はアスペルギルス属になります。毒素は作らないカビで発酵食品に利用されます。下の写真は、ニンジンについていたカビを培養したものになりますが毒素を出すもがも含まれています。
「自家製コウジカビで味噌を作ってみた」のような動画投稿などを最近見かけるようになりましたがとても危ない行為になります。
市販で売られているコウジカビはしっかりと管理された環境で培養されたものですが自分で培養したものであるとちょっとでも環境中から菌を拾ってしまうとそれが増えてしまい、本来増やしたいコウジカビではなかったということになります。見た目で判断することはできません。
よく食中毒などは食べて変な味がしたら腐敗でおいしければ発酵というような基準がありますが、カビによる食中毒は味などで判断できません。さらに食中毒の症状がすぐに泡われるものではなく数年後に現れてくるのでカビによって起きた食中毒と気が付かないこともあります。 じわじわとカビ毒が肝臓などに蓄積し肝炎、肝臓ガンなどに発展してきます。このカビ毒は加熱しても変化しないので調理なのをしても毒素は残ってしまいます。
自分でコウジカビを増やして利用したいという人もいるかもしれませんが、コウジカビはしっかりしたところでしっかりと増やした市販のものを使用することをオススメします。
今日も最後までお読みいただきありがとうございました。